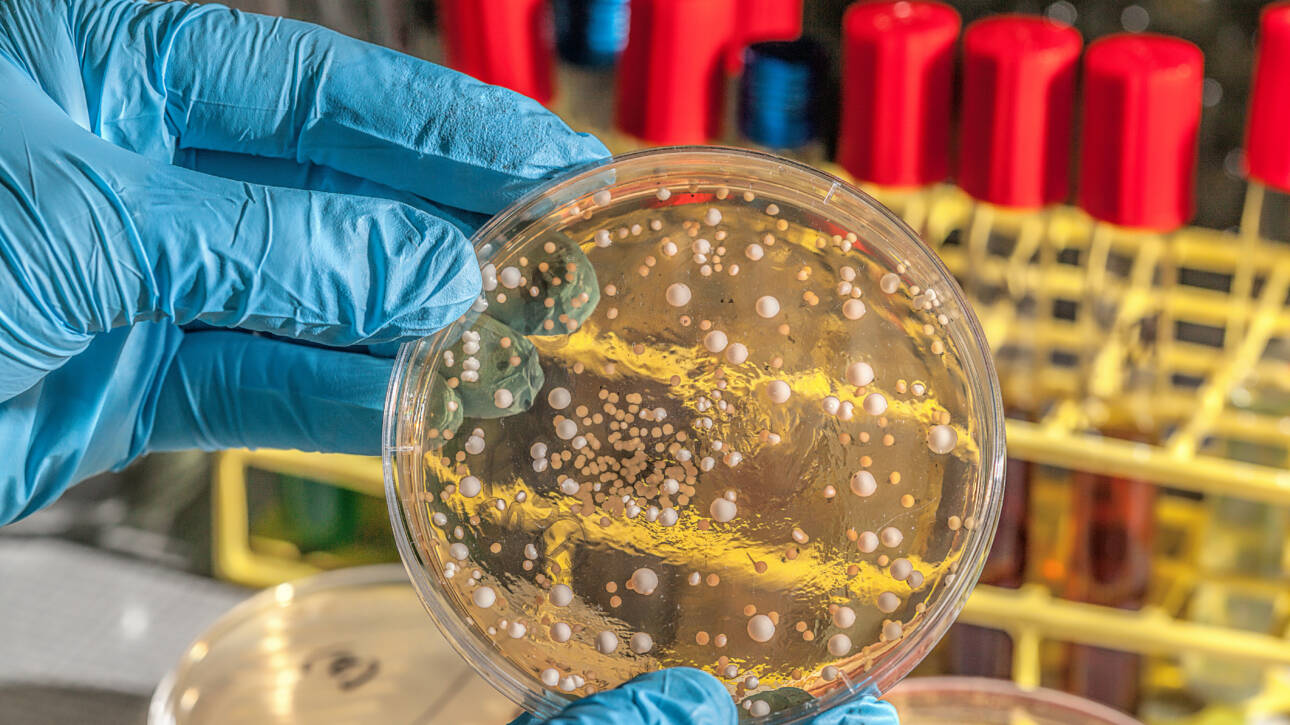

5-year survival for some aggressive cancers is under 35%.
- Our polymolecular approach targets metabolic plasticity, reducing metastasis and enabling immune system activation.
- Aberrant metabolism alters the tumor microenvironment, reducing immune response and allowing cancer cells to spread quickly.
Pioneering Bio-Based Therapies

Botanical science for the future of oncology
Phairilab develops clinically validated therapies and consumer health products derived from native medicinal plants — powered by a fully integrated sourcing and R&D model.
Plant-Based Cancer Drugs in FDA & EMA Approval
Ethnobotany-inspired cancer drugs targeting tumor metabolism are eligible for the FDA-EMA approval pathway. Under the FD&C Act, botanical drugs are regulated under the same legal framework as synthetic drugs, requiring:
- IND — Investigational New Drug (to initiate clinical trials)
- NDA — New Drug Application (for market authorization)

The FDA’s 2016 Botanical Drug Guidance explicitly allows polymolecular formulations, accepting that botanical medicines may contain multiple active constituents with controlled variability.


OTC Line
We bridge regenerative agriculture, pharmacology and biotechnology to turn traditional plant intelligence into scalable, evidence-based therapeutics, with supplements and dermocosmetics designed for patient support, prevention and long-term immune balance.

CS-DiviCare
- Antioxidant activator of innate immune responses
- In process for new food (EFSA)
- Phase I in normal individuals
- (NCT03663881) and Phase II in covid patients (NCT04410510) completed.

CS-SkinBiorepair
- Reduces inflammation generated by gamma-radiation

DiviPet
- Supplement for veterinary cancer control
From regenerative agriculture to pharmaceutical-grade APIs, we bridge science, biodiversity and global health needs.


